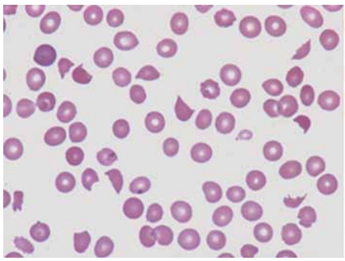
Enunciado 4918571-1

Foram encontradas 600 questões.
A leucemia de células pilosas (LCP) é um distúrbio linfoproliferativo indolente de células B que representa apenas
2% de todas as leucemias; é caracterizada patologicamente por linfócitos neoplásicos com projeções citoplasmáticas na superfície celular.
Em relação a ela, é correto afirmar:
Em relação a ela, é correto afirmar:
Provas
Questão presente nas seguintes provas
Mulher de 56 anos portadora de leucemia mieloide
aguda de alto risco é avaliada para transplante de célula
tronco hematopoietica (TCTH) compatível de seu irmão.
Ela é O positiva, e ele é A negativo. Submetida a protocolo
de condicionamento não mieloablativo. No dia 0, a célula-
-tronco do sangue periférico é infundida sem incidentes.
No dia 8, apresenta hemoglobina de 6 g/dL (abaixo dos
9 g/dL do dia anterior). Encontra-se assintomática e sem
qualquer evidência de sangramento.
O quadro mais provavelmente reflete:
O quadro mais provavelmente reflete:
Provas
Questão presente nas seguintes provas
MJS, branca, 65 anos procurou nosso ambulatório com
queixas de dor articular em membros superiores e inferiores iniciada há dois anos, acompanhada de fogachos,
prurido intenso e vermelhidão em todo corpo que se agravavam após o banho, no período menstrual e em exposição solar. Surgimento de manchas eritematosas em
traumas leves que demoravam a cicatrizar. História prévia
de infecções de vias aéreas superiores e pneumonia
na infância. Negou doenças crônicas, tabagismo ou
alcoolismo.
Ao exame físico eupneica, acianótica anictérica obesa. Epiderme e mucosas hipercoradas, baço palpável a 4 cm do rebordo costal esquerdo (RCE). Hb 17,7 g/dL, Ht 56% leucócitos 8.000/mm3 diferencial normal, plaquetas 703.000/mm3.
Em relação à patologia mais provável, é correto afirmar:
Ao exame físico eupneica, acianótica anictérica obesa. Epiderme e mucosas hipercoradas, baço palpável a 4 cm do rebordo costal esquerdo (RCE). Hb 17,7 g/dL, Ht 56% leucócitos 8.000/mm3 diferencial normal, plaquetas 703.000/mm3.
Em relação à patologia mais provável, é correto afirmar:
Provas
Questão presente nas seguintes provas
diabetes insulino dependente.
Provas
Questão presente nas seguintes provas
A maioria dos linfomas de células do manto (LCM) consiste de pequenos linfócitos com núcleos chanfrados e
pode exibir padrões de crescimento difusos ou vagamente nodulares. O imunofenótipo do LCM é único, normalmente expressando CD5, FMC7 e CD43, embora não
tenha expressão de CD10 e CD23.
Praticamente todos os LCM carregam a translocação que resultam na superexpressão da ciclina D1 a saber:
Praticamente todos os LCM carregam a translocação que resultam na superexpressão da ciclina D1 a saber:
Provas
Questão presente nas seguintes provas
Paciente sexo feminino, 56 anos, iniciou com tontura e
cefaleia com melhora espontânea. Apresentou quadro
semelhante sete dias após o primeiro episódio associado
a anemia e plaquetopenia, sendo então encaminhada
para o nosso hospital. Evoluiu com confusão mental,
realizando TC de crânio sem evidência de lesões isquêmicas. Nos exames, apresentou Hb 8,8 g/dL, plaquetas
14.000/mm3
, bilirrubina total 1,8 mg/dL; bilirrubina indireta 1,2 mg/dL, Coombs Direto negativo, TTPA 24,2 seg;
RNI 1,1 fibrinogênio 288 mg/dL, ureia 72 mg/dL e
creatinina 1,45 mg/dL. Realizada BMO mostrando normocelularidade, sem fibrose reticulínica e cariótipo 46,XX.
Evoluiu com déficit neurológico focal à esquerda, sendo
constatado AVCi por RNM.
Esfregaço de sangue periférico

(Arquivo pessoal; imagem usada com autorização)
A hipótese diagnóstica mais provável e a conduta inicial mais adequada são, respectivamente:
Esfregaço de sangue periférico
(Arquivo pessoal; imagem usada com autorização)
A hipótese diagnóstica mais provável e a conduta inicial mais adequada são, respectivamente:
Provas
Questão presente nas seguintes provas
Elranatamabe é um anticorpo biespecífico que se liga
ao BCMA em células plasmáticas e CD3-epsilon em
células T, levando à citólise seletiva das células que
expressam BCMA.
Em relação a ele, é correto afirmar:
Em relação a ele, é correto afirmar:
Provas
Questão presente nas seguintes provas
Paciente RHT, 10 anos, sexo masculino, compareceu
em 2012 para avaliação devido fimose e testículo retrátil
bilateral. Durante o exame físico, foi notada a ausência
do primeiro quirodáctilo direito, manchas café-com-leite
no hipocôndrio direito e região lombar, além da presença de fáceis sindrômica. Mãe relatou leve hipoacusia.
Apresentava bom estado geral. Foram evidenciados
plaquetopenia e anemia (hemácias 4,2 milhões/mm3
;
hemoglobina 11,9 g/dL; hematócrito 39%; VCM 81 fL;
HCM 28,1 pg; CHCM 32,4 g/dL; plaquetas 97.000/mm3
;
leucócitos 11.600/mm3
).
O teste utilizado para confirmação diagnóstica é o de
O teste utilizado para confirmação diagnóstica é o de
Provas
Questão presente nas seguintes provas
É um erro inato do metabolismo do grupo das doenças
lisossômicas de depósito. De herança autossômica recessiva, resultante da deficiência da beta-glicosidase ácida
ou beta-glicocerebrosidase, que leva ao acúmulo de glicolipídios nos macrófagos principalmente em baço, fígado,
medula óssea e pulmão. As manifestações clínicas ou
fenotípicas vão depender do grau de deficiência da
enzima, existindo três tipos. A do tipo I, forma não neuropática, afeta crianças e adultos com hepatoesplenomegalia, anemia, trombocitopenia, leucopenia e lesões ósseas.

Tal descrição e imagens correspondem ao observado na

Tal descrição e imagens correspondem ao observado na
Provas
Questão presente nas seguintes provas
Constitui critério mandatório para o diagnóstico de
síndrome POEMS:
Provas
Questão presente nas seguintes provas
Cadernos
Caderno Container